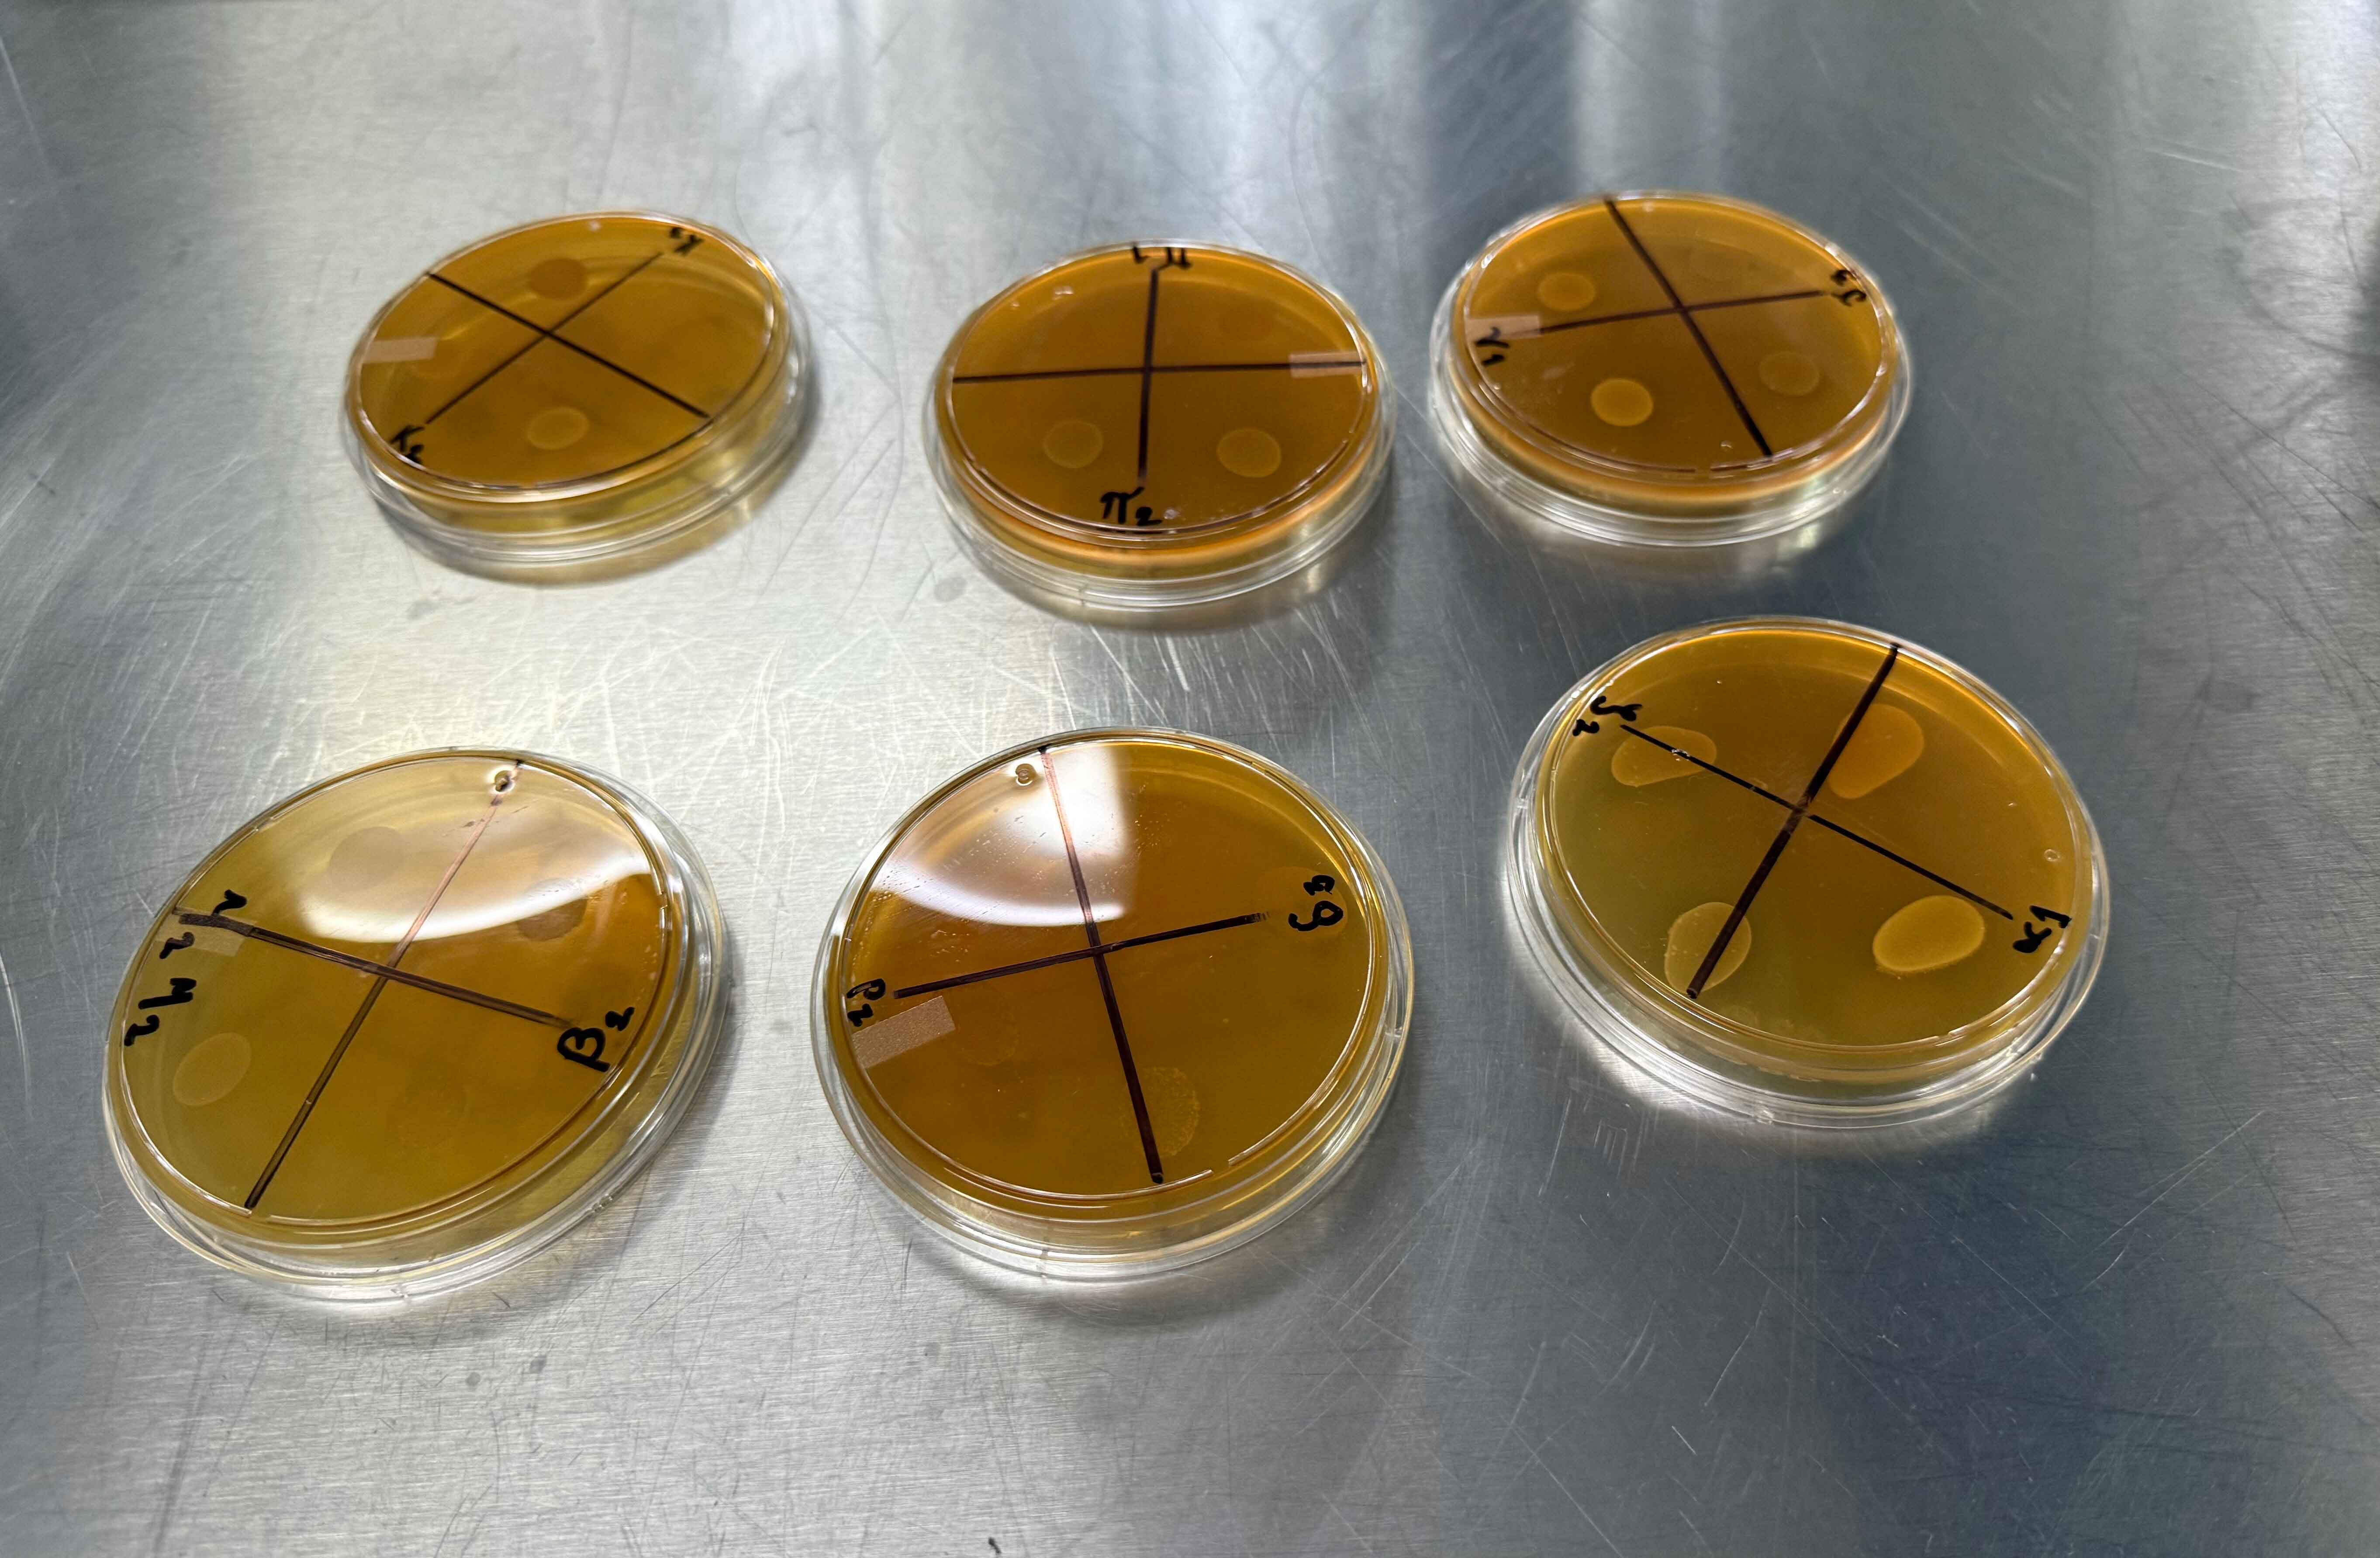

La Universidad Autónoma de Querétaro (UAQ), a través de la Facultad de Química (FQ), realiza un estudio sobre el pulque con el objetivo de caracterizar sus propiedades físicas, químicas y microbiológicas, buscando aprovechar su potencial beneficio para la salud humana.
El proyecto está liderado por la Dra. Sofía María Arvizu Medrano, coordinadora de la Especialidad en Inocuidad de Alimentos y profesora investigadora de la FQ, con la colaboración de Marco Antonio Verduzco Tornel, estudiante de la Maestría en Ciencia y Tecnología de los Alimentos. La investigación se centra en identificar las características únicas de esta bebida ancestral en Querétaro, ya que existen estudios en otras regiones del país, pero no en el estado.
Para ello, el equipo se acercó a la Asociación de Productores de Maguey y Pulque del Estado de Querétaro, recolectando muestras de aguamiel, pulque joven y pulque semilla de cinco productores en los municipios de Cadereyta de Montes y El Marqués.
Los análisis realizados revelaron la presencia de bacterias lácticas y levaduras con propiedades probióticas, las cuales pueden inhibir microorganismos dañinos como Salmonella y Listeria monocytogenes. Asimismo, se identificó una diversidad de aromas en el pulque de la región, incluyendo notas florales, de miel y frutales.
La Dra. Arvizu Medrano destacó que la investigación continuará explorando las capacidades de las levaduras y bacterias aisladas para su uso en procesos de fermentación de otros productos, así como su potencial para inhibir microorganismos patógenos. Además, el estudio busca promover el valor cultural y gastronómico del pulque, resaltando su importancia en la sanidad pública.